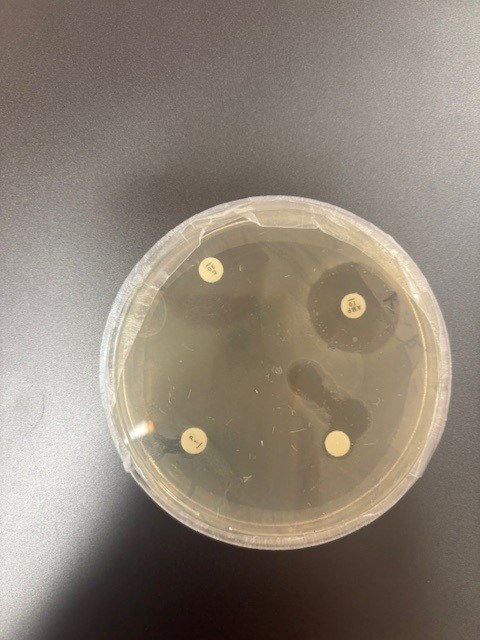

The BEST (Bioscience, Environmental Science, Sustainability & Technology) program seamlessly integrates the environment, the marine world and science with our community. This learning area empowers students to cultivate specific scientific skills and knowledge in fields such as biomedical science, biomechanics, environmental science and technology. Situated near Long Hollow Heathland, Ricketts Point Sanctuary and Balcombe Reserve, our school offers students unparalleled practical opportunities for environmental learning, as well as having cutting edge technology within the classroom.
Year 7 & 8
In Years 7 & 8, students cover core curriculum which includes Biological, Chemical, Physical and Earth and Space Sciences.
Year 9 & 10
In Years 9 & 10, students have the opportunity to select semester-based specialisms, allowing them to pursue their interests in specific sciences. These specialisms encompass key disciplines such as Biology, Chemistry, Physics and Psychology. Each specialism offers ‘real-life’ applications, engaging students in developing a scientific worldview while preparing them for the VCE Science.
| BEST Specialisms | |
|---|---|
| Biological Science | Chemical & Physical Science |
| Be a Vet | Back to the Future |
| CSI: Crime Scene Investigation | Chemistry in the Kitchen (Real World Reactions from 2027) |
| Disease and Discovery | Green Chemistry (Chemistry for Tomorrow from 2027) |
| DNA to Dinosaurs | The Big Bang |
| Marine Sanctuary |
VCE
Learning through practical application and real-world connections is emphasised in our VCE Sciences. Courses offered include Biology, Chemistry, Physics and Psychology, each spanning Units 1-4.
Co-curricular
Students are encouraged to attend the Lunchtime Learning Club, BEST Club, Attenborough Club, Climate Action Club, Earth Club, VCE Study Groups and Home Learning Support, as well as participate in competitions when they arise. A Marine Ambassadors program is also available.

Cutting-edge Resources
Equipped with cutting-edge tools and resources, our students extend their theoretical understanding of science. Highlights include:
- Wireless sensors for data collection across all year levels
- A variable temperature water bath for experiments
- Geiger counters for radiation detection
- A diverse fossil collection enriching our studies
- Access to a comprehensive array of physics equipment
- Various models for anatomical study
- A collection of STELR equipment for renewable energy research
- Class set of gel electrophoresis machines to create and study DNA profiles
Year 7 BEST
Year 8 BEST
Year 9 & 10 Back to the Future
Year 9 & 10 Be a Vet
Year 9 & 10 Chemistry in the Kitchen/In Your Element
Year 9 & 10 CSI: Crime Scene Investigation
Year 9 & 10 Disease & Discovery
Year 9 & 10 DNA to Dinosaurs
Year 9 & 10 Green Chemistry/Chemistry for Tomorrow
Year 9 & 10 Marine Sanctuary
Year 9 & 10 Survival Skills
Year 9 & 10 The Big Bang
VCE Biology
VCE Chemistry
VCE Physics
VCE Psychology
Watch: Balloon Dogs & Observational Learning
2026
How do we learn by watching others? Our Unit 3 Psychology students explored the process of observational learning, watching, modelling and replicating the steps to create balloon dogs. A hands-on way to see how attention, retention, reproduction, motivation and reinforcement influence learning in action.